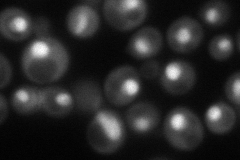
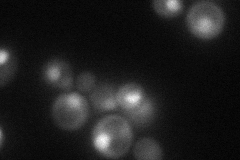

View description
TFIIA small subunit; involved in transcriptional activation, acts as antirepressor or as coactivator; homologous to smallest subunit of human and Drosophila TFIIA
Localization:
Intensity:
Fold change:
Significance:
-
C’ GFP library in SD

below threshold15.48 -
N' NOP1pr-GFP in SD
nucleus79.4194 -
N' TEF2pr-mCherry in SD
cytosol45.7393 -
N' NATIVEpr-GFP in SD

nucleus27.3041 -
N' TEF2pr-VC and Cyto-VN in SD

nucleus29.209 -
C’ GFP library in SD+DTT

cytosol17.151.1No -
C’ GFP library in SD+H2O2

cytosol16.611.07No -
C’ GFP library in Starvation Media

cytosol16.761.08No -
C’ GFP library on the background of Pup2-DaMP

below threshold -
C’ GFP library on the background of CCT mutant

below threshold14.6560.94647No
